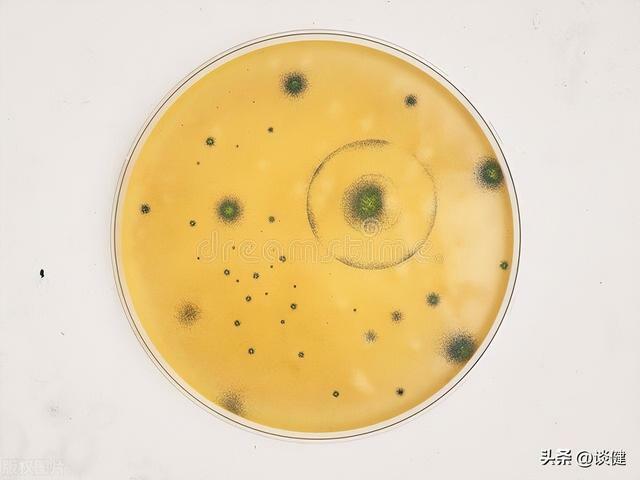

「只是被貓、狗舔了一下,就要鋸掉四肢,千萬不要被他們呆萌的外表所矇騙,這些甜蜜的殺手就在你的身邊……」
「大多數狗的唾液裡面都含有一種犬咬二氧化碳嗜纖維菌,它會導致人體的組織損傷和器官衰竭甚至死亡。」
......
在現實生活之中,有一些人總喜歡養些貓、狗之類的寵物,然而它們在向主人示好表示親切的時候,也總喜歡舔人。絕大多數人被貓狗舔了以後,就會害怕染上致命的疾病。因此,網絡上就有傳言稱「千萬不要被貓狗舔了,不然會截肢或致命!」那麼,這是真的嗎?

一、被貓舔後會因唾液而喪命?
人類和貓狗等動物身上都有許多共生菌,巴氏桿菌和韓瑟勒巴通氏菌是兩種貓狗身上常見的細菌,但這兩種菌對人體的致病風險低,且通常是經貓狗咬抓或舔有傷口處才有可能感染,感染後也多是輕症。
此外,貓舌的倒刺也沒有那麼危險,且雖然貓的口水可能有巴氏桿菌、巴爾通體,但因為貓而感染巴氏桿菌、巴爾通體等細菌的人並不多。根據相關資料顯示,巴氏桿菌俗稱為貓抓熱或貓抓病,一般也為輕症。因此,網絡傳言說被貓舔會感染巴氏桿菌、巴爾通體等細菌,甚至可能因而昏迷、喪命,與事實不符。
需要進一步說明的是,巴通氏菌的患者大多是被貓咬傷或抓傷,或是舔到人的傷口而感染,身體沒有傷口是不容易被感染的。絕大多數病例會在咬、抓傷的部位出現紅色丘疹,並出現倦怠及發燒等症狀, 但巴通氏菌並不會人傳人,且人類感染巴通氏菌通常不嚴重,多數免疫功能正常的一般病患,在2到3個月內即使不給藥也能恢復,但有免疫缺陷的患者則應該接受抗生素治療。
最後,雖然巴氏桿菌確實會造成人類生病,其中又以多殺性巴氏桿菌是導致人類巴斯德氏菌感染的主要病原體,但巴氏桿菌的感染途徑很多,泥土、環境中可能就有,因此不一定是從貓狗身上接觸此菌。且因為貓狗接觸到此菌也不一定會造成感染,通常是衛生習慣不佳,或本身有傷口,且本身是免疫疾病或其它重大疾病的病患,才有較高風險感染此病。但如果是被貓咬傷,傷口清理與殺菌消毒的工作是必要的。
綜合以上,巴氏桿菌不只存在於貓狗身上,人體與環境中都有,致病風險極低;韓瑟勒巴通氏菌俗稱為貓抓熱或貓抓病,一般免疫力正常的成人在感染後能自行痊癒,但是並不常見。

二、被狗舔會感染犬咬二氧化碳嗜纖維菌嗎?
犬咬二氧化碳嗜纖維菌在人與動物的口腔中都有,但被感染的機率並不高,但建議大家仍應維持個人健康習慣。
犬咬二氧化碳嗜纖維菌為犬咬症的病原,是貓狗唾液里常見的細菌,但在環境中也有,且不是容易被傳染的疾病,雖然傳染途徑包括被貓狗咬抓傷,或是在有傷口的狀況下跟貓狗親密接觸,但通常傷口是較深及受傷時沒有積極消毒治療的狀況才造成感染,且被狗咬傷時也常跟其它細菌一起混合感染,但近年沒有聽說有病例報告。
犬咬二氧化碳嗜纖維菌是一種革蘭氏陰性菌,存在於貓狗的口腔中,屬於唾液中常見細菌,通常被感染的機率不高。根據加拿大病例訊息指出,犬咬症於1976年首次發現後,截至2013年,全球累計200例。

三、對於與貓狗互動的疾病風險管理,有什麼建議?
貓狗的唾液中本來就有一些常見細菌,但人類接觸不一定會感染,即使感染也多為輕症,除非是免疫功能較差的幼童、老人或病患,不然一般健康的人甚至不用藥也能痊癒。雖然國外確實曾有數起疑似因為貓狗而感染細菌而致命的病例,但是在我國並沒有聽過病例報告。
在現實生活之中,想要避免從寵物身上感染病菌,應該限制寵物貓接觸病原,例如限制外出、維持乾淨的飼養環境等。一般人也應該維持觸碰貓狗之後就洗手的日常習慣;飼主有傷口時,傷口應避免接觸到貓狗,而免疫力較弱、或甚至免疫低下的人,更應該避免接觸貓狗排泄物等即可。平常要防止被貓抓或咬,如被抓咬受傷應迅速清潔傷口並消毒,嚴重的話應該趕快就醫即可。

需要補充的是,我們的環境中本來就有很多細菌,貓狗只是環境的一環,不只貓狗的唾液,人類的唾液也有細菌,且細菌不是致病的唯一因素,因此說光被貓狗舔就會致病也言過其實,重點還是在於個人是否有做好風險控管。
所謂風險控管包括個人衛生與健康管理,例如是否勤洗手、接觸寵物或寵物的排泄物後是否洗手、如果有傷口是否有適當照護。如果自身因疾病或特殊狀況不適合接觸犬貓,則應有更多評估與防範。
最後也提醒,犬貓身上的細菌與它們生活的環境息息相關,若有飼養寵物(不限於貓狗),都應讓它們在健康乾淨的環境中,限制外出並注意外出時的安全與衛生、規律性進行適當除蚤、除蟲。
綜合以上,貓狗的唾液有常見細菌,但一般健康成人感染多為輕症;而貓狗只是環境的一環,建議平日就該做好個人衛生與健康管理,並照顧好寵物,讓寵物在健康乾淨的環境中生活。